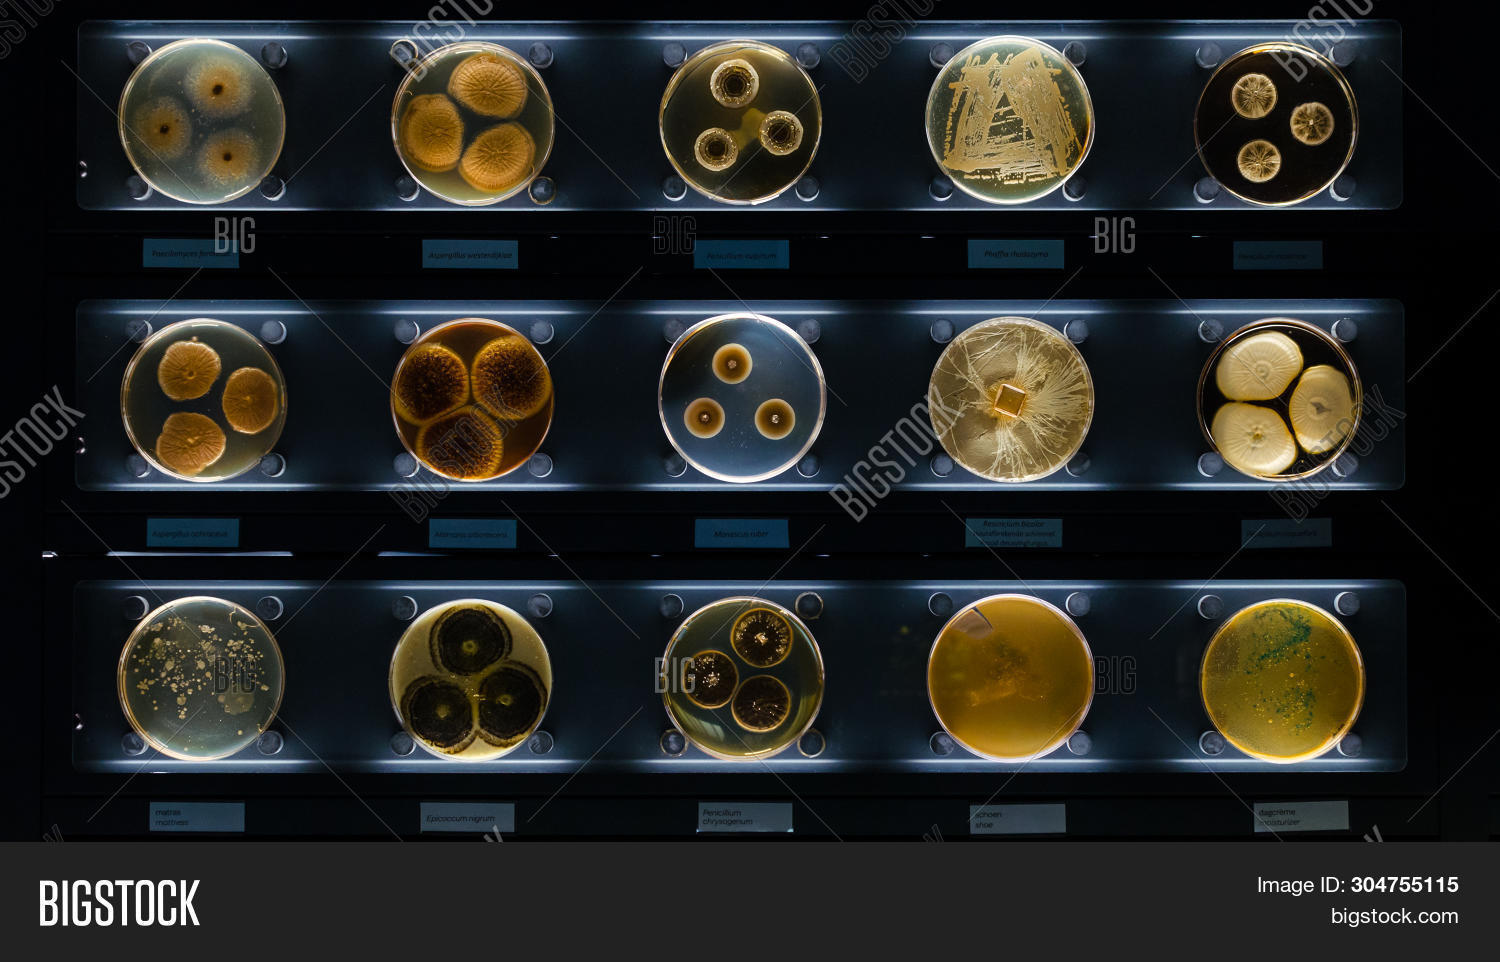

ปิด
ภาพ
ภาพ
different samples with kinds of bacterias living at common household items- mattress, shoe, moisturizer. Penicillium chrysogenum, epicoccum nigrum.
| Stock Photo ID: 304755115 |
| ลิขสิทธิ์: Annet_ka |
มีให้สำหรับการใช้สิทธิ์ใช้งานแบบขยาย
ดาวน์โหลดทุกขนาดในราคาเดียว
| 5 ภาพ ต่อวัน | $0.53 / ภาพ | $79 |
| 10 ภาพ ต่อวัน | $0.33 / ภาพ | $99 |
| 50 images per month | $1.58 / ภาพ | $79 |
เครดิตจะใช้ได้นานถึงหนึ่งปี
| 10 เครดิต | $35 | |
| 25 เครดิต | ประหยัด 44% | $49 |
| 100 เครดิต | ประหยัด 52% | $169 |
| 500 เครดิต | ประหยัด 72% | $495 |
บันทึกภาพตัวอย่างของภาพนี้ไปยังไดรฟ์ Google